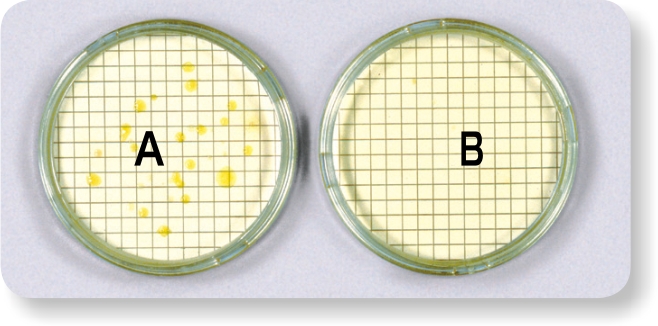

in the internal distribution systems of non-priority and priority buildings
and in certain ships pursuant to Directive (EU) 2020/2184
For the water distributed through the internal water systems, designers, builders, maintainers and managers of the internal water network, depending on their specific powers and responsibilities, must help ensure that the parameter values of the water supplied by the drinking water management service, in compliance with the regulations at the point of delivery, are maintained up to the tap of the individual users while also ensuring that the water is conveyed with the adequate flow rates and pressure levels, keeping the chemical, physical, microbiological and organoleptic characteristics substantially unchanged.
The device comes in several models so it can be used in all types of water systems.
This innovative device is the result of research and development, using proprietary technology, and offers advantages and benefits that were previously unattainable, allowing for achieving health, energy, technical and environmental goals.
Non-exhaustive list of some priority and non-priority buildings with the obligation
of risk assessment and management for the safety of water intended for human consumption according to Directive (EU) 2020/2184
Hospitals
Barracks
Pools
Nursing homes
Beauty and Spa Centres
Restaurants
Healthcare facilities
Shopping centres
Catering businesses
Hotels
Sports centres
Schools
Tourist facilities
Buildings with accommodation
Stations
Beach facilities
Public buildings
Exhibition venues
Workplaces
Fountains
Childcare facilities
Condos
Irrigation systems
Recreational facilities
Residences
Correctional facilities
Cooling towers
Airports
Schools
Universities
Hospitality industry
Ships
Hydromassage tubs
All buildings listed in Directive (EU) 2020/2184 require the implementation of the RAD (risk assessment document for the safety of water in the internal distribution systems of buildings) and the hygiene self-check plan, which is the responsibility and care of the GIDI (this new position is responsible for the oversight and management of water distribution in the building and they can either be the owner of the building or their delegate).
On request, the devices can be equipped with units for remote control in the cloud

Mod. PH 200 with by-pass

Mod. PH 200

Mod. PH 350/3 with by-pass
The Physico® model suitable for the system to be treated is identified by our technicians, who will carry out the sizing, free of charge, and will provide your installer with the instructions for the correct installation.
If the installer or the end customer does not follow our technicians’ instructions, the guarantee of functionality will fall exclusively under their responsibility.
The items are on sale at our production and marketing site (even a single piece can be purchased). You can also contact us by phone or email through your installer/dealer:
Tel. +39 049 91 25 688 - info @physico.eu

Examples of devices installed on by-pass

University Department of Industrial Chemistry

Piping before installing Physico®

Piping after installing Physico®

Coil with
untreated water
Calcite: 30%
Aragonite: 70%
Coil with
treated water
Calcite: 0%
Aragonite: 100%
Visual check of the external condition of copper heat exchangers after the test performed at the University of Padua

WATER AS IT IS
10÷20 μm Calcium Carbonate Crystals

WATER TREATED WITH PHYSICO®
0.03 μm Calcium Carbonate Crystals
Electron microscope photo inside the heat exchangers after the test performed at the University of Padua
The tests carried out at the University of Padua certify the effectiveness of the treatment by the PHYSICO® device against the formation of limescale deposits in heat exchangers
University Department of Biology and Natural Sciences
Effect of the electromagnetic field on the
total bacterial at 37°Celsius present in well water
A: untreated water - B: treated water

Effect of the electromagnetic field on
faecal coliforms present in river water
A: untreated water - B: treated water

Effect of the electromagnetic field on
total coliforms present in river water
A: untreated water - B: treated water

Results obtained from microbiological tests carried out at the University of Milan
Microbiological tests carried out at the University of Milan certify that PHYSICO® produces an effective and constant bactericidal activity with a consequent reduction of pathogenic microorganisms present in the water, achieving a residual self-sanitizing effect even on the pipes of the plumbing system.
Countless international epidemiological studies have confirmed that Calcium, Magnesium, Potassium and Fixed Residue must be present in water for human consumption as they are essential micronutrients for the body and act as deterrents for various chronic degenerative diseases, including cardiovascular diseases.



For water safety in the internal distribution systems of non-priority
and priority buildings and in certain ships pursuant to Directive (EU) 2020/2184
Analyses and certificates of application compliance for the treatment of water for human consumption have been carried out at both certified university and research laboratories.
Analysis, research and certificates performed by:
University of Padua
University of Milan
IMQ - Italian Quality Mark Institute
CSA - Research Institute
Compliant with Directive (EU) 2020/2184 of the European Parliament and of the Council of 16 December 2020 on the quality of water intended for human consumption.

PHYSICO® patented and manufactured by Tecnoacque® with its registered office in Via Vò di Placca, 18 - 35020 Due Carrare - Padua - Italy - P.IVA IT02556080287 (Tax Identification Number) - Tel. +39 049 91 25 688 - info@tecnoacque.com - www.tecnoacque.com - info@physico.eu - www.physico.eu